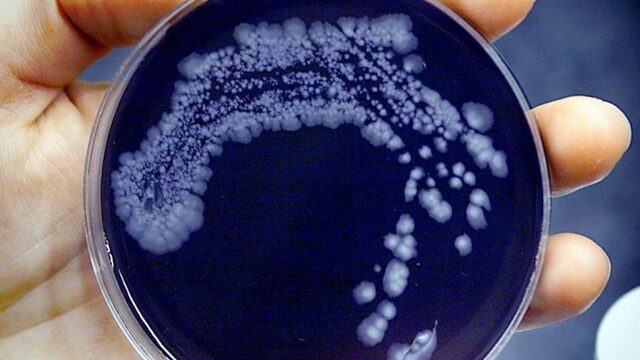
Gaan er straks meer mensen dood aan bacteriën dan aan kanker?

Overzicht
Videos

Klein meisje

Yara van Kerkhof geniet van vrijspraak

Het zwaar bevochten goud van Ada Kok

Passie, strijd en een zwaarbevochten punt; zo klonk PSV-Tottenham

Dit waren de bepalende momenten van een jaar Rutte III

Stage lopen in een buitenlands weeshuis? Doe het niet

Dit moet je weten over George Soros
Gaan er straks meer mensen dood aan bacteriën dan aan kanker?

Explosieven gestuurd naar Witte Huis, Obama, Hillary Clinton en CNN

De jaren 90 waren beter

Je diepste dagboekgeheimen delen op tv, zou jij het doen?

'Weinig vrouwen in de wereld zijn zo sterk als Kiki Bertens'